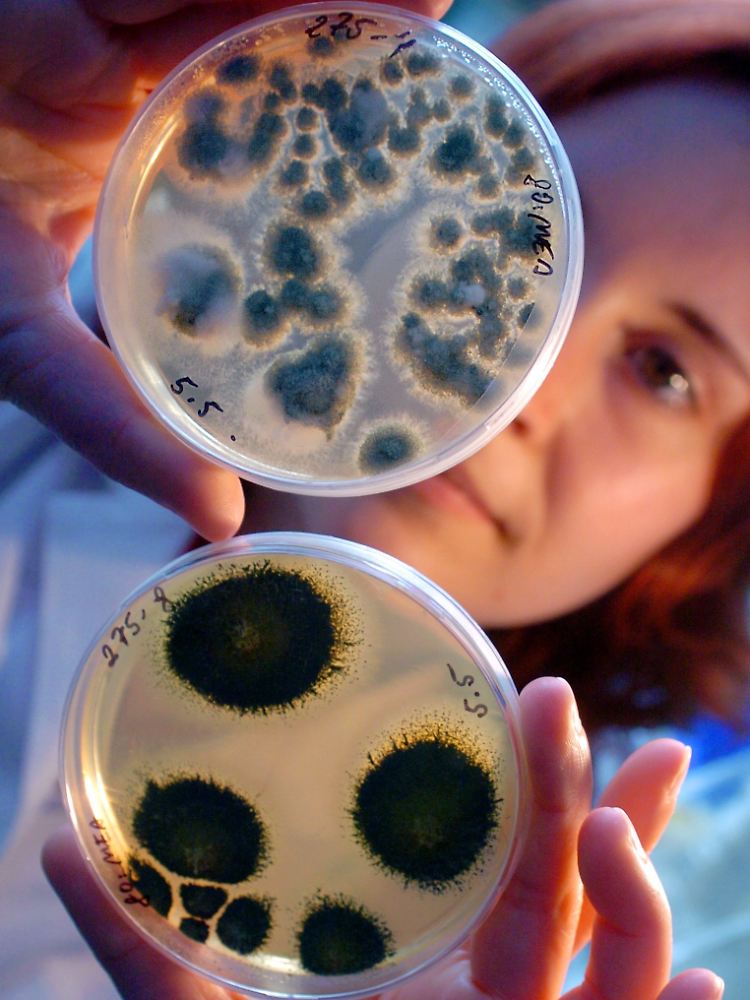

Viel mehr als bisher angenommen Pilzsporen in der Luft gemessen
13.07.2009, 09:30 Uhr
Gezüchtete Schimmelpilze in Glasschalen.
(Foto: picture-alliance / dpa/dpaweb)
Die Menge und Artenvielfalt von Pilzsporen in der Luft sind nach Untersuchungen von Mainzer Forschern wesentlich höher als bisher angenommen. Mit Erbgutanalysen identifizierten sie mehrere hundert Pilzarten in der Luft, in jedem Kubikmeter zählten sie zwischen 1000 und 10.000 Pilzsporen, wie das Max-Planck-Institut für Chemie und die Johannes Gutenberg-Universität in Mainz mitteilten.
Diese erste systematische Studie über Pilz-Erbgut in der Luft zeige, dass der Anteil der Pilze, die Allergien auslösen, Pflanzen schädigen und Krankheiten erregen könnten, größer sei als gedacht. Mit der neuen Methode ließen sich biologische Schwebteilchen besser charakterisieren. Solche Untersuchungen seien unter anderem wichtig für die Überwachung von genmodifizierten Pflanzen.
Schlauch- und Ständerpilze
"Insgesamt kennen wir heute über 100.000 Arten von Pilzen", erläuterte Wissenschaftlerin Janine Fröhlich von der Uni Mainz. Hochrechnungen gingen aber davon aus, dass es mehr als 1,5 Millionen Arten gibt. Die in der Luft gefundenen Arten gehörten überwiegend zu den Gruppen der Schlauch- oder der Ständerpilze, zu deren Vertretern sowohl beliebte Speisepilze wie Champignons oder Trüffel, aber auch potenzielle Krankheitserreger wie Schimmel- und Rostpilze zählen.
Beide Gruppen schleudern zur Vermehrung ihre Sporen aktiv in die Luft. Wenn sie von Menschen oder Tieren eingeatmet werden oder in Kontakt mit Pflanzen kommen, können viele von ihnen Allergien oder Krankheiten auslösen. Für die jüngste Studie haben Forscher über ein Jahr Fein- und Grobstaub aus der Luft gefiltert und auf DNA untersucht.
Wichtige Informationsträger
Über den Nachweis der Sporen könne etwa untersucht werden, ob sich die Ökosysteme durch den Klimawandel verändern, teilte Ulrich Pöschl vom Max-Planck-Institut für Chemie und Leiter der Studie mit. Zudem sei es darum gegangen, welche Rolle Pilzsporen bei der Bildung von Niederschlag spielen können. "Pilzsporen und andere biologische Aerosolpartikel können als Kondensations- und Kristallisationskeime für Wassertropfen und Eiskristalle dienen und dazu beitragen, dass Wolken, Nebel und Niederschlag entstehen." Eine genaue Analyse der Anzahl und Eigenschaften der Pilzsporen in der Luft hilft daher, die Abläufe im Klimasystem besser zu verstehen.
Quelle: ntv.de, dpa